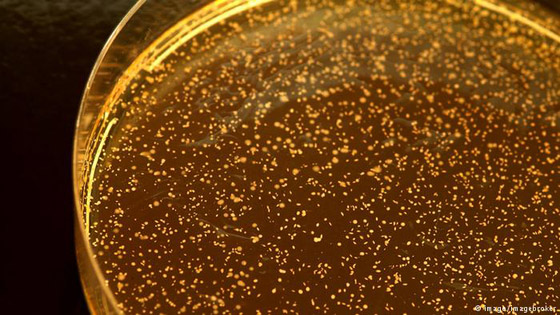

منظمة الصحة العالمية شددت مؤخرا على أهمية سلامة المنتجات الغذائية وحمايتها من التلوث وخطر البكتيريا والفيروسات والفطريات التي تهدد صحة الإنسان، لكن هناك منها ما هو مفيد ولا نستغني عنه.

خبز كهذا وقد نما عليه فطر يمثل خطرا كبيرا على الصحة. كما أن الفطر الموجود في بعض أنواع الجبن قد يتسبب في الإصابة بالحساسية.

هذا النوع من الفطيرات (Aspergillus nigers) يكوّن انزيمات تفتت الكربوهيدرات والدهون والبروتينات، فيتم استخدامها في المنتجات الغذائية ومساحيق الغسيل.

كلوستريديوم بوتولينوم، يتم استخدامه في عمليات التجميل الجراحية فهو مثل البوتكس يقوم بتنعيم البشرة. إلا أنه سام جدا إذا ما تواجد في المواد الغذائية.

براعم الحلبة على سبيل المثال، كانت من المنتجات المحببة عام 2011 لدى المهتمين بالطعام الصحي. إلى أن تبين إصابتها بنوع من البكتيريا بعد اختلاطها ببذور حلبة مصرية وهي بكتيريا EHEC ما تسبب في إصابة العديد من الناس في ألمانيا.

بكتيريا الـ EHEC تنتج سما يدمر خلايا جدار الأمعاء وقد يصل الأمر إلى مهاجمتها للمخ والكلى.

هناك أنواع من بكتيريا إشريكيا القولونية التي تنتج في الأمعاء الغليظة وتساعد على بناء العظام والخلايا وتنقية الدم. وتستخدم هذه البكتيريا في انتاج الإنسولين وهرمونات النمو.
اللاكتوباسيلس هي نوع من البكتيريا تستخدم في منتجات الألبان مثل الزبادي والحليب الرايب. إلا أن هناك أنواعا من هذه البكتيريا التي قد تكون ضارة بالصحة.

عطيفة البكتيريا الملتوية تنتقل من الحيوانات إلى البشر. وقد تنتقل أيضا عبر أكل اللحوم النيئة جيدا.

السلمونيلا من البكتيريا المعروفة، وهي عادة ما تصيب المرء عند أكل بيض غير مسلوق جيدا. والتيفود من أنواع الأمراض الناتجة عن السلمونيلا. 32 مليون شخص يصابون سنويا بهذا المرض أغلبهم بسبب عدم توفر مياه شرب نظيفة.

نوروفيروس ينتقل من الإنسان عبر التقيء أو الفضلات العضوية. جزيئات صغير من هذا الفيروس تكفي لانتشار العدوى وقد يلوث المياه والمواد الغذائية.















